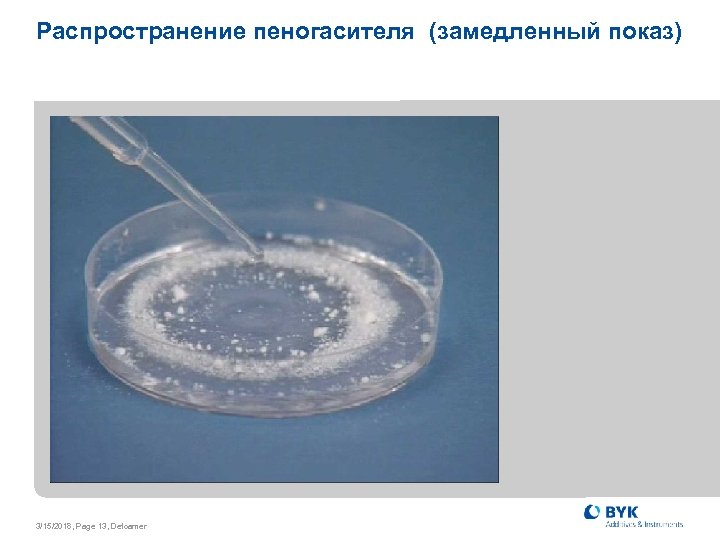
Распространение пеногасителя (замедленный показ) 3/15/2018, Page 13, Defoamer

2970c7fd6a235f6cd71d6dc6da35b89f.ppt
- Количество слайдов: 33

Пеногасители для печатных красок Heinz Utzig , BYK , Глава направления «Добавки для печатных красок» Москва 2011

Содержание • Что такое пена - стабилизация пены • Механизм действия пеногасителей • Классы пеногасителей • Методы испытаний пеногасителей 3/15/2018, Page 2, Defoamer

Источники пены в печатных красках • адсорбированный воздух (пигменты, наполнители) • реакционные газы (например влажность в 2 K-PU системах ) • вовлеченный воздух (производство, нанесение) 3/15/2018, Seite 3, Entschäumer

Как избежать пенообразования • оптимизация производственного процесса • смачивание сухих компонентов • минимизация пеностабилизирующих компонентов • корректировка процесса нанесения 3/15/2018, Seite 4, Entschäumer

Подъем пузырька к поверхности 2 r ~ __ V V = скорость подъема r = радиус пузырька = вязкость жидкости 3/15/2018, Seite 5, Entschäumer

Разрушение пузырька на поверхности Чистые жидкости не образуют пены ! 3/15/2018, Page 6, Defoamer

Чистые жидкости не пенятся 3/15/2018, Seite 7, Entschäumer

Стабилизация пены гидрофобная неполярная гидрофильн. полярная ПАВ 3/15/2018, Seite 8, Entschäumer

Стабилизация пены поверхностно-активным веществом 3/15/2018, Seite 9, Entschäumer

Типы пены Мокрая пена Сухая пена Пена – дисперсия газа в жидкости 3/15/2018, Page 10, Defoamer

Пеногаситель : механизм действия 3/15/2018, Seite 11, Entschäumer
Распространение пеногасителя (замедленный показ) 3/15/2018, Page 13, Defoamer

Пеногашение 3/15/2018, Seite 14, Entschäumer

Определение Коэффициенты вхождения и распространения • коэффициент вхождения E = F + int - D • коэффициент распространения S = F - int - D • пеногаситель: E > 0 and S > 0 F = поверхностное натяжение жидкости int = межфазное поверхностное натяжение жидкость/пеногаситель D = поверхностное натяжение пеногасителя 3/15/2018, Page 15, Defoamer

Пеногашение 3/15/2018, Seite 16, Entschäumer

Классы пеногасителей для водных систем • пеногасители на основе минеральных масел • силиконовые пеногасители • полимерные пеногасители не содержащие силикона 3/15/2018, Page 17, Defoamer

Состав пеногасителей на основе минерального масла Минеральное масло Гидрофобные частицы Эмульгатор Модифицированный полисилоксан 3/15/2018, Page 18, Defoamer % 85 - 95 1 -3 3 -6 0, 5 - 3

Пеногашение с помощью гидрофобных частиц гидрофобная частица ламелла пены дестабилизация 3/15/2018, Seite 19, Entschäumer

Полидиметилсилоксаны CH 3 (CH 3)3 Si O CH 3 Si (CH 3)3 x совместимые x несовместимые 2 - 30 45 - 230 выравнивание скольжение 3/15/2018, Page 20, Defoamer не используются в водных ЛКМ 380 - 1500 пеногашение 1800 - 2900 молотковый эффект

Силиконовые пеногасители CH 3 (CH 3)3 Si O Si CH 3 O Si (CH 2)x CH 3 O Si(CH 3)3 m Полиэфир R n простой полиэфир: EO(этиленоксид), PO(пропиленоксид), EO/PO 3/15/2018, Page 21, Defoamer

Силиконовые пеногасители для водных печатных красок простой полиэфир = РО Сухое вещество % Гидрофобные частицы Носитель/растворитель BYK-017 100 - BYK-018 100 Полигликоль MW >1000, гидрофобный BYK-019 60 BYK-021 100 Полигликоль MW >1000, гидрофобный BYK-022 100 полигликоль MW >1000, гидрофобный BYK-023 20 вода 3/15/2018, Page 22, Defoamer монометиловый эфир дипропиленгиколя

Силиконовые пеногасители для водных печатных красок полиэфир = EO или EO/PO Сухое вещество % Гидрофоб -ные частицы Носитель/растворитель 10 Бутилгликоль / этилгексанол / уайтспирит BYK-024 100 полигликоль MW <1000, гидрофильный/гидрофобный: эмульгируемый BYK-025 20 BYK-028 100 полигликоль MW >2000, гидрофильн. BYK-044 57 вода BYK-093 100 полигликоль MW >2000, гидрофильн. BYK-094 100 полигликоль MW <1000, гидрофильн. /гидрофобн: эмульгир. BYK- 1798 3/15/2018, Page 23, Defoamer монометиловый эфир дипропиленгликоля

Выбор силиконового пеногасителя для водных систем Повышение эффективности пеногашения • менее гидрофобные • более совместимые • более гидрофобные • менее совместимые старт: BYK-028 BYK-093 BYK-025 BYK-024 BYK-094 BYK-022 BYK-024/BYK-025 комбинация BYK-021 BYK-023 BYK-022/BYK-024 комбинация 3/15/2018, Page 24, Defoamer BYK-044 BYK-018 BYK-019 BYK-017

диспергирование Усилия сдвига Выбор силиконового пеногасителя BYK-017 BYK-044 BYK-019 BYK-021 BYK-018 BYK-022 BYK-023 BYK-024 BYK-094 постановка на тип BYK-093 BYK-028 введение на заключительном этапе 3/15/2018, Page 25, Defoamer BYK-025 Продолжительность введения

Пеногасители для органорастворимых систем и систем без растворителя • силиконовые пеногасители • полимерные пеногасители не содержащие силикона • силиконовые / полимерные пеногасители • Силиконы и акрилаты с пеногасящими свойствами 3/15/2018, Page 26, Defoamer

Силиконовые пеногасители для органорастворимых/ безрастворительных печатных красок выше BYK-065 полярность BYK-1798 BYK-066 N BYK-141 BYK-067 A BYK-071 BYK-080 A ниже 3/15/2018, Seite 27, Entschäumer эффективность выше

Полимерные не содержащие силикона пеногасители для органорастворимых/ безрастворительных печатных красок без силикона выше полярность BYK-051 BYK-A 550 BYK-052 BYK-1752 BYK-053 BYK-A 560 BYK-057 BYK-055 BYK-054 BYK-1790 низкая ниже 3/15/2018, Seite 28, Entschäumer эффективность выше

Силикон-/ полимерные пеногасители для органорастворимых/ безрастворительных печатных красок выше BYK-A 530 полярность BYK-070 BYK-088 BYK-060 N низкая ниже 3/15/2018, Seite 29, Entschäumer эффективность выше

Поверхностные добавки с пеногасящими свойствами Силиконы Акрилаты • BYK-077 • BYK-354 • BYK-322 • BYK-352 • BYK-323 • BYK-392 • BYK-320 • BYK-359 3/15/2018, Page 30, Defoamer

Выбор пеногасителя Пеногашение Оптимум Дефекты совместимый / растворимый несовместимый / нерастворимый Пена Стабилизация пены 3/15/2018, Page 31, Defoamer

Влияние совместимости Пеногаситель в трех различных растворителях слева: слишком несовместим помутнение в центре: слишком совместим стабилизация пены справа: оптимальный баланс прозрачность, отсутствие пены 3/15/2018, Page 32, Defoamer

Обобщение • предупреждение образования пены 1. производство 2. нанесение • правильный выбор добавок 1. смачивающе-диспергирующие добавки 2. поверхностные добавки • применение пеногасителя 3/15/2018, Seite 33, Entschäumer

ANTI-TERRA®, ATEPAS®, BYK®-DYNWET®, BYK®-SILCLEAN®, BYKANOL®, BYKETOL®, BYKOPLAST®, BYKUMEN®, DISPERBYK®, DISPERPLAST®, ISAROL®, LACTIMON®, NANOBYK®, SILBYK® и VISCOBYK® зарегистрированные товарные знаки компании BYK-Chemie. AQUACER®, AQUAMAT®, AQUATIX®, CERACOL®, CERAFAK®, CERAFLOUR®, CERAMAT®, CERATIX® и MINERPOL® -зарегистрированные товарные знаки компании BYK-Cera. Данная информация соответствует самому современному уровню наших знаний. В связи с разнообразием рецептур, условий производства и переработки все вышеупомянутые рекомендации должны быть скорректированны с учетом специфических особенностей каждого производства. Данная информация не гарантирует свойств продукта в каждом отдельном случае. Мы не несем ответственности в случаях использования продукта за пределами рекомендуемых областей применения, включая случаи нарушения патентных прав. , Page 34, János Hajas, technical support manager
2970c7fd6a235f6cd71d6dc6da35b89f.ppt